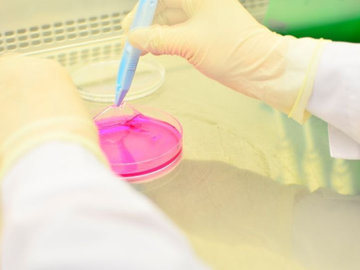
В Бурятии создан уникальный аналог живой кожи

Врачам удалось извлечь из желудка ребенка раскрытую булавку без полостной операции
 Здоровье
Здоровье
 Здоровье
Здоровье
Врачам Краснодарской детской краевой больницы удалось, используя эндоскопический метод, извлечь из желудка 10-месячного ребенка раскрытую булавку, которая воткнулась в стенку органа.
Исследователи объяснили, почему храп особенно опасен для женщин
 Здоровье
Здоровье
 Здоровье
Здоровье
Американские ученые выяснили, что храп во сне влияет на здоровье как мужчин, так и женщин.
- Исследователи выяснили, как лишний вес влияет на развитие рака
- Избавляемся от кровоточивости десен
- Половина водоемов на Земле засорена лекарствами
- Роспотребнадзор: в Индии вспыхнула лихорадка Зика
- В России разработали прибор для засыпания
- Витамины, которые полезны осенью и зимой
- Исследователи разработали специальный клей, который затягивает раны за 60 секунд
- Исследователи: седые люди живут дольше
- Грудные импланты могут спровоцировать аутоиммунные болезни
- Японские специалисты разработали уникальный лазерный скальпель
Чрезмерное употребление соли провоцирует развитие рассеянного склероза
 Здоровье
Здоровье
 Здоровье
Здоровье
Исследователи из США выяснили, что употребление соли в больших количествах может вызвать развитие опасного заболевания — рассеянного склероза.
В Бурятии создан уникальный аналог живой кожи
 Здоровье
Здоровье
Здоровье
Здоровье
В Бурятии создали модифицированную коллаген-ламининовую матрицу, которая является аналогом живой кожи. В России нет ничего подобного, только в США и Европе.
От каких болезней могут вылечить пиявки?
 Оригинальные методики
Оригинальные методики
 Оригинальные методики
Оригинальные методики
С давних времен обществу известен метод лечения пиявками - гирудотерапия. Данным способом пользовался сам Гиппократ.
Не все каши одинаково полезны
 Здоровье
Здоровье
 Здоровье
Здоровье
Каждый из нас слышал, насколько полезна отварная крупа. Многие употребляют кашу в пищу сами и готовят ее своим детям. Однако, не все каши являются полезными.
- Немецкие исследователи разработали нанароботов для лечения заболеваний
- Исследователи США: душевая лейка - источник опасных микроорганизмов
- Как вылечить обветренные губы
- Врачи советуют офисным работникам пить больше воды
- Исследователи выяснили, как остановить развитие рака
- Как "взбодрить" мозг: советы экспертов
- Исследователи из Вашингтона: мед нужно употреблять каждый день
- Болезнь Бехтерева: как диагностировать и чем лечить
- Канадские исследователи: питьевая вода поможет избавиться от хронической усталости
- Медики предупредили: поздний ужин вреден для здоровья

